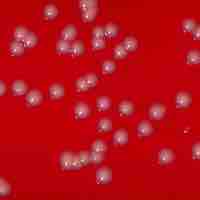
Thumbnail

Chapter 17
Industrial Microbiology
By Boundless
There are various types of microorganisms that are used for large-scale production of industrial items.

The isolation of molecular products from microbes is considered to be a key component of molecular biology research.

Primary and secondary metabolites are often used in industrial microbiology for the production of food, amino acids, and antibiotics.

Large-scale fermentations are key to the production of numerous products ranging from food to pharmaceutical items.

Industrially produced antibiotics are produced by fermentation, where the source microorganism is grown in large liquid growth medium.

Microorganisms and plants can synthesize many uncommon amino acids and vitamins.

A steroid is a type of organic compound that contains a characteristic arrangement of four cycloalkane rings that are joined to each other.

Enzymes are biological molecules that catalyze (increase the rates of) chemical reactions.

Microorganisms from sewage can cause human disease, but can also negatively affect important ecosystems on which humans rely.

Wastewater is treated in 3 phases: primary (solid removal), secondary (bacterial decomposition), and tertiary (extra filtration).

Water is purified with filters to remove larger protozoans, and by chemical or UV disinfection to kill bacteria and other small pathogens.

The production of alcohol beverages is a process that involves the active participation of microorganisms, most often yeasts.

Vinegar is a food product made by acetic acid bacteria that can ferment the alcohol in alcoholic liquids to acetic acid.

Many organic compounds, like citric acid, are produced industrially by microorganisms.

Fungi are used as food or as producers of a variety of food products (bread, wine, beer, etc. ) or compounds used in different industries.

Edible algae have been used as food for centuries in many coastal regions all over the world.

Fermented dairy products have been prepared and consumed by people for centuries due to their high nutritional values.

Fermentation is the conversion of carbohydrates to alcohols and carbon dioxide or organic acids using microorganisms.

Food spoilage is the process in which food deteriorates to the point it is not edible to humans or its quality of edibility becomes reduced.

Food preservation is the process of treating food to stop or slow down spoilage, loss of quality, edibility, or nutritional value.